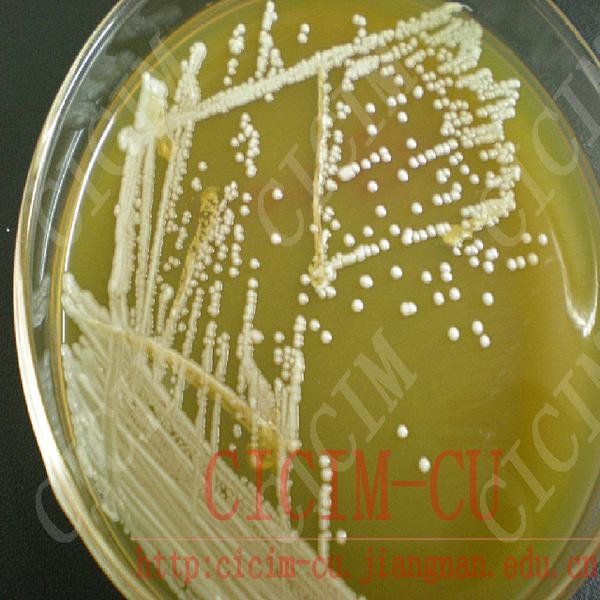
伯顿毕赤酵母

毕赤酵母

杰丁毕赤酵母
图片尺寸373x350
毕赤酵母|北纳生物
图片尺寸740x547
毕赤酵母的优缺点
图片尺寸624x431
赛道威毕赤酵母及其用途
图片尺寸1339x1213
一种毕赤酵母菌及其在饲料发酵中的应用
图片尺寸1232x1272
毕赤酵母
图片尺寸800x600
蛋白表达系统之毕赤酵母表达系统介绍
图片尺寸560x472
妮雅丝巴斯德毕赤酵母祛痘去痘精华液控油液凝胶淡化痘印痘坑
图片尺寸800x800
巴斯德毕赤酵母表达系统ppt
图片尺寸920x690
肠道酵母增加哮喘风险
图片尺寸500x281
一株耐乳酸的产酯毕赤酵母-爱企查
图片尺寸1357x1023
毕赤酵母smd1163菌种
图片尺寸3024x4032
毕赤酵母x33,km71,km71h,gs115,smd1168,smd1163_酵母_细胞株/菌种
图片尺寸400x265
膜醭毕赤酵母
图片尺寸399x391
伯顿毕赤酵母
图片尺寸600x600
珠海高活性干酵母厂家直销牛羊猪养殖饲料发酵剂 有益菌增殖 诱食饲料
图片尺寸1080x1920
蛋白表达系统之毕赤酵母表达系统介绍
图片尺寸650x235
毕赤酵母电转之后g418筛选时候,全都长满了
图片尺寸900x675
请问实验室有毕赤酵母的朋友可否给一下显微镜检或者培养皿菌落的照片
图片尺寸366x275
生物制药技术毕赤酵母表达系统及应用ppt38页
图片尺寸1152x864